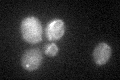
YHR106W
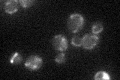
YHR106W

View description
Mitochondrial thioredoxin reductase involved in protection against oxidative stress, required with Glr1p to maintain the redox state of Trx3p; contains active-site motif (CAVC) present in prokaryotic orthologs; binds NADPH and FAD
Localization:
Intensity:
Fold change:
Significance:
-
C’ GFP library in SD

mitochondria18.62 -
N' NOP1pr-GFP in SD

mitochondria182.932 -
N' TEF2pr-mCherry in SD

punctate,mitochondria113.693 -
N' NATIVEpr-GFP in SD

below threshold16.234 -
N' TEF2pr-VC and Cyto-VN in SD

#N/A0 -
C’ GFP library in SD+DTT
mitochondriaN/AN/ANo -
C’ GFP library in SD+H2O2

mitochondriaN/AN/ANo -
C’ GFP library in Starvation Media
mitochondriaN/AN/AYes -
C’ GFP library on the background of Pup2-DaMP

mitochondria -
C’ GFP library on the background of CCT mutant

mitochondriaN/AN/ANo
